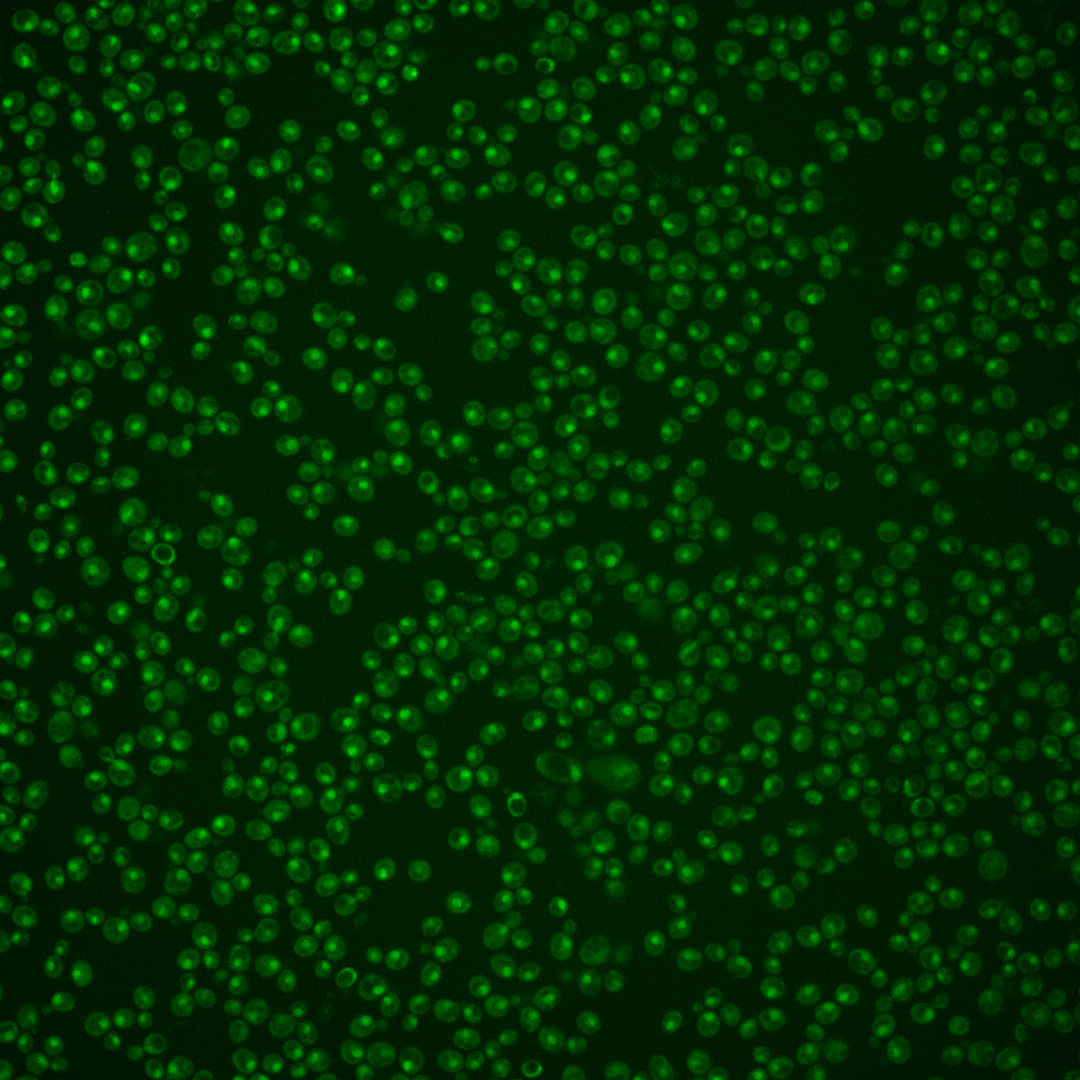
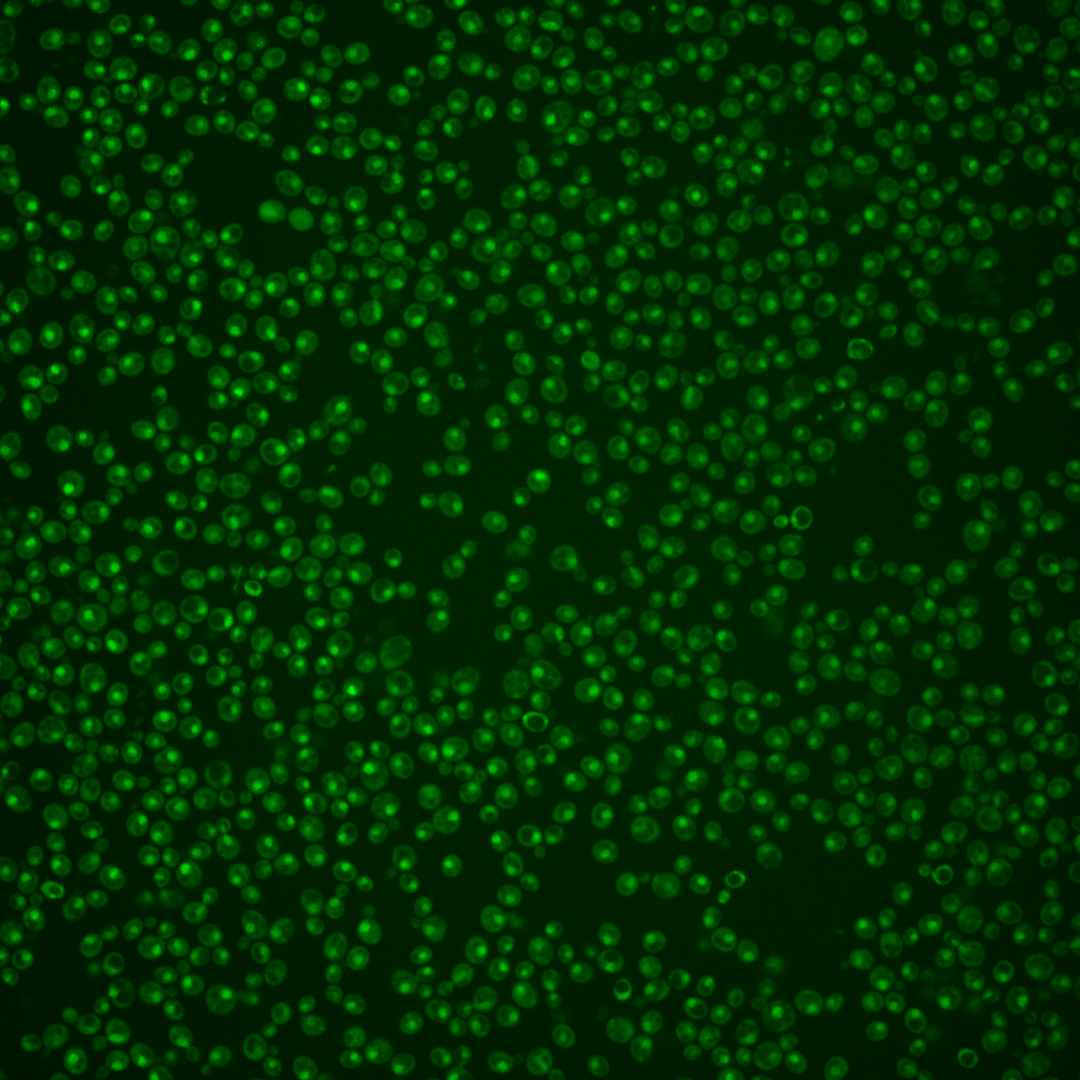
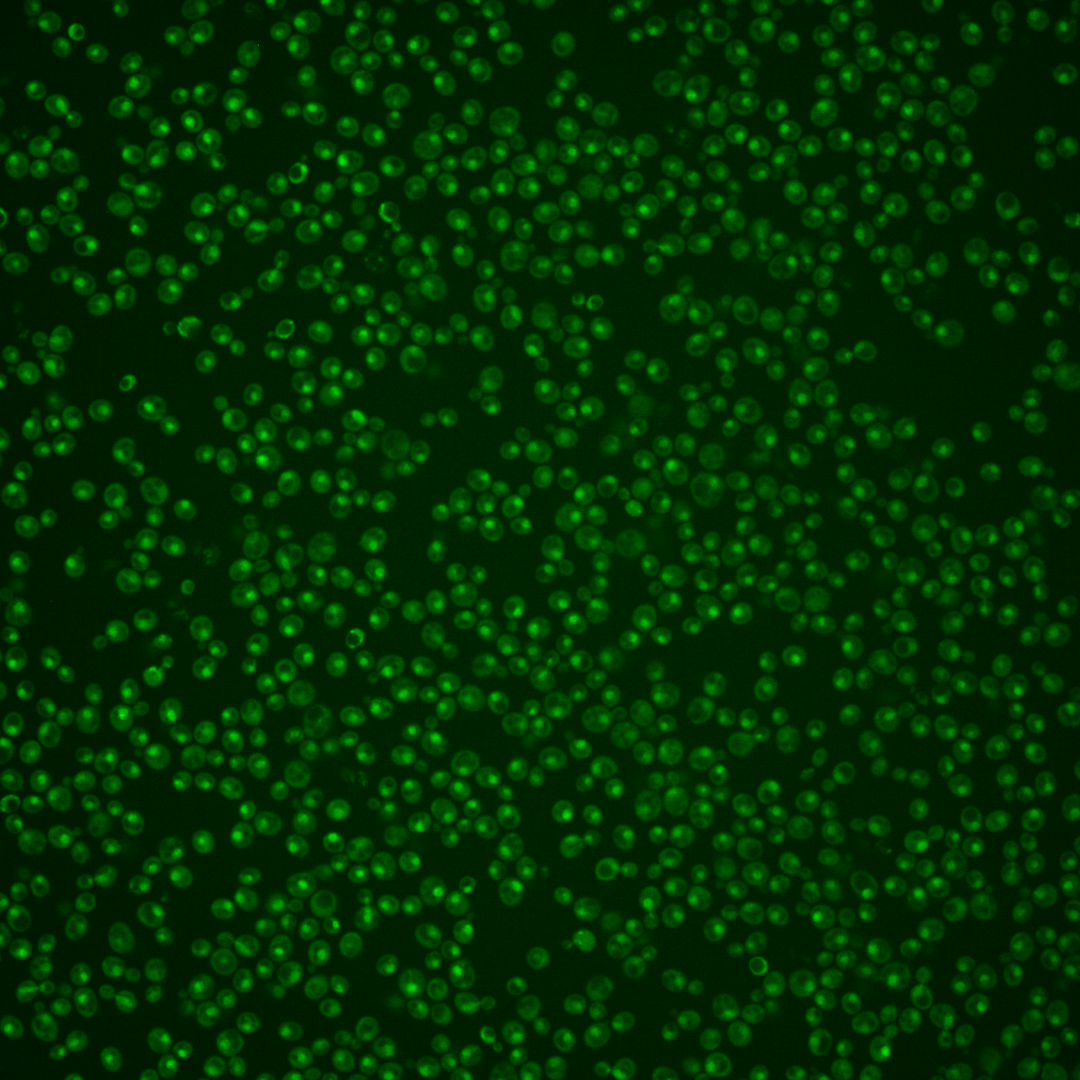
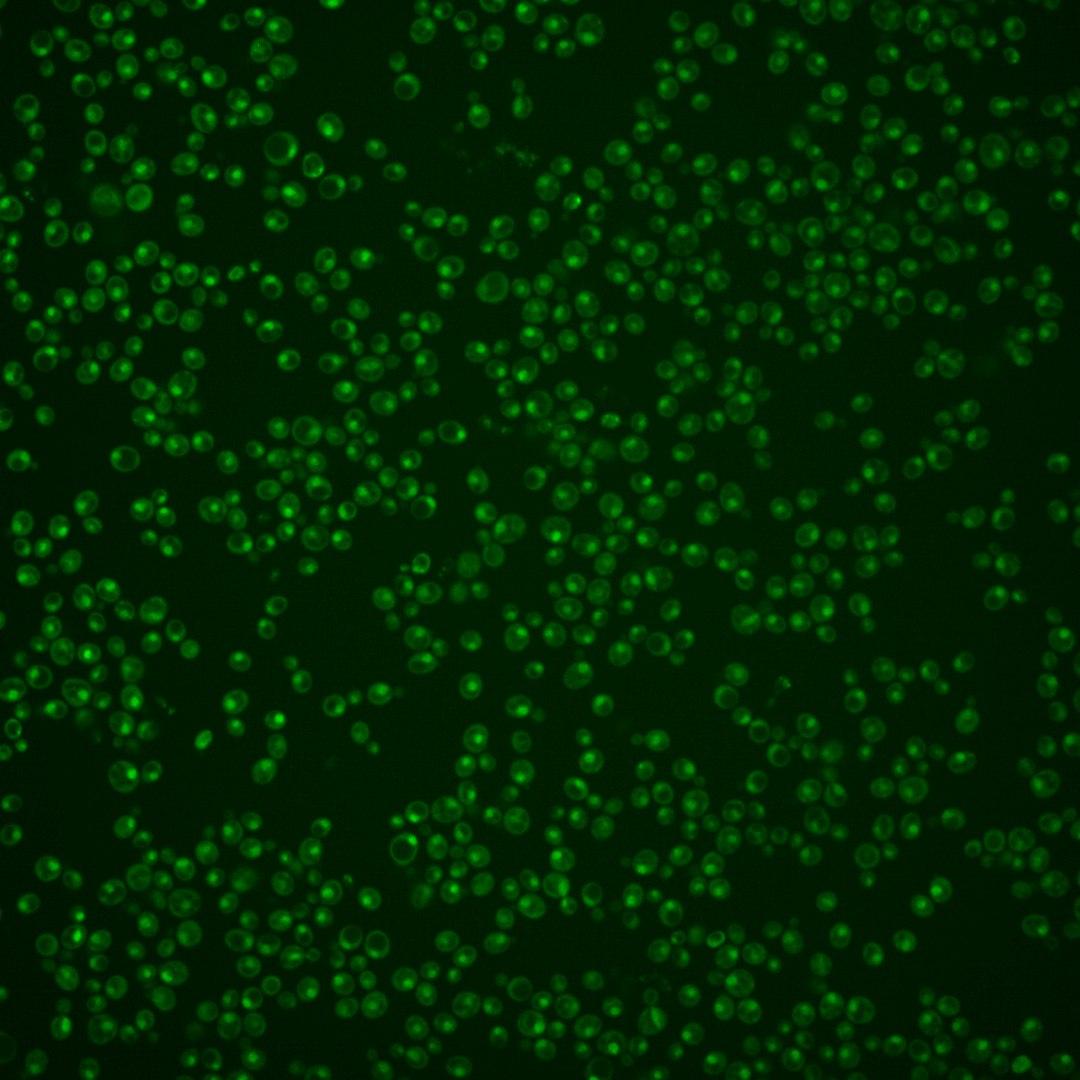

| Standard name | |
|---|---|
| Human Ortholog | |
| Description | Zn(II)2Cys6 family transcription factor; positively regulates sterol uptake genes under anaerobic conditions; involved in hypoxic gene expression; represses filamentation-inducing genes during vegetative growth; positively regulates mating with SUT2 by repressing expression of genes that act as mating inhibitors; repressed by STE12; relocalizes from the nucleus to the cytoplasm upon DNA replication stress; SUT1 has a paralog, SUT2, that arose from the whole genome duplication |
Micrographs




















































































Sub-cellular Localization
Yeast GFP Assignment
Protein Abundance
Localization Change
External localization resources
| ensLOC | DeepLoc | |||||||||||||||||||||||
|---|---|---|---|---|---|---|---|---|---|---|---|---|---|---|---|---|---|---|---|---|---|---|---|---|
| Localization | WT1 | WT2 | WT3 | RAP60 | RAP140 | RAP220 | RAP300 | RAP380 | RAP460 | RAP540 | RAP620 | RAP700 | HU80 | HU120 | HU160 | rpd3Δ_1 | rpd3Δ_2 | rpd3Δ_3 | WT1 | WT2 | WT3 | AF100 | AF140 | AF180 |
| Cortical Patches | 0 | 0 | 0 | – | 0 | 0 | 0 | 1 | 0 | 0 | 0 | 0 | 0 | 0 | 0 | – | 0 | 1 | 0 | 0 | 0 | 2 | 0 | 0 |
| Bud | 0 | 0 | 0 | – | 0 | 0 | 0 | 1 | 1 | 1 | 1 | 2 | 0 | 0 | 0 | – | 0 | 1 | 4 | 5 | 0 | 4 | 8 | 6 |
| Bud Neck | 0 | 0 | 0 | – | 0 | 0 | 4 | 4 | 0 | 0 | 2 | 3 | 1 | 3 | 1 | – | 0 | 0 | 0 | 1 | 0 | 1 | 0 | 5 |
| Bud Site | 0 | 0 | 0 | – | 0 | 0 | 0 | 2 | 3 | 2 | 3 | 8 | 0 | 0 | 0 | – | 0 | 0 | – | – | – | – | – | – |
| Cell Periphery | 0 | 0 | 0 | – | 0 | 0 | 0 | 0 | 0 | 0 | 0 | 0 | 0 | 0 | 0 | – | 1 | 0 | 0 | 0 | 0 | 0 | 0 | 0 |
| Cytoplasm | 17 | 20 | 1 | – | 14 | 22 | 51 | 63 | 54 | 64 | 24 | 69 | 23 | 99 | 244 | – | 56 | 30 | 7 | 13 | 0 | 11 | 22 | 29 |
| Endoplasmic Reticulum | 0 | 0 | 0 | – | 0 | 0 | 1 | 2 | 1 | 0 | 1 | 1 | 0 | 0 | 1 | – | 7 | 11 | 0 | 0 | 0 | 2 | 2 | 1 |
| Endosome | 4 | 1 | 0 | – | 0 | 0 | 1 | 0 | 1 | 0 | 0 | 1 | 0 | 13 | 4 | – | 24 | 18 | 4 | 6 | 0 | 2 | 2 | 8 |
| Golgi | 3 | 0 | 1 | – | 0 | 0 | 0 | 0 | 0 | 0 | 0 | 0 | 0 | 0 | 0 | – | 1 | 0 | 2 | 1 | 1 | 0 | 0 | 0 |
| Mitochondria | 22 | 133 | 1 | – | 0 | 3 | 16 | 28 | 107 | 91 | 83 | 128 | 3 | 2 | 1 | – | 21 | 8 | 4 | 11 | 0 | 3 | 7 | 9 |
| Nucleus | 202 | 246 | 29 | – | 5 | 4 | 8 | 27 | 31 | 50 | 42 | 59 | 132 | 99 | 20 | – | 77 | 59 | 198 | 255 | 46 | 176 | 135 | 108 |
| Nuclear Periphery | 0 | 0 | 0 | – | 0 | 0 | 0 | 0 | 0 | 0 | 0 | 0 | 0 | 0 | 0 | – | 0 | 0 | 0 | 0 | 0 | 0 | 0 | 1 |
| Nucleolus | 6 | 1 | 0 | – | 0 | 0 | 0 | 0 | 0 | 2 | 0 | 2 | 1 | 0 | 0 | – | 1 | 1 | 20 | 25 | 3 | 20 | 16 | 20 |
| Peroxisomes | 0 | 0 | 0 | – | 0 | 0 | 0 | 0 | 0 | 0 | 0 | 0 | 0 | 0 | 0 | – | 0 | 0 | 0 | 0 | 0 | 0 | 0 | 0 |
| SpindlePole | 6 | 10 | 1 | – | 0 | 1 | 4 | 5 | 0 | 3 | 0 | 4 | 5 | 3 | 1 | – | 14 | 9 | 17 | 18 | 4 | 16 | 15 | 32 |
| Vac/Vac Membrane | 19 | 13 | 1 | – | 3 | 1 | 2 | 3 | 3 | 1 | 5 | 8 | 8 | 26 | 40 | – | 42 | 21 | 25 | 47 | 5 | 37 | 38 | 44 |
| Unique Cell Count | 251 | 340 | 33 | 22 | 30 | 79 | 117 | 156 | 165 | 119 | 214 | 163 | 239 | 295 | 197 | 131 | 292 | 394 | 67 | 288 | 257 | 279 | ||
| Labelled Cell Count | 279 | 424 | 34 | 22 | 31 | 87 | 136 | 201 | 214 | 161 | 285 | 173 | 245 | 312 | 244 | 159 | 292 | 394 | 67 | 288 | 257 | 279 | ||
Yeast GFP Assignment
Protein Abundance
| Screen | WT1 | WT2 | WT3 | RAP60 | RAP140 | RAP220 | RAP300 | RAP380 | RAP460 | RAP540 | RAP620 | RAP700 | HU80 | HU120 | HU160 | rpd3Δ_1 | rpd3Δ_2 | rpd3Δ_3 | AF100 | AF140 | AF180 |
|---|---|---|---|---|---|---|---|---|---|---|---|---|---|---|---|---|---|---|---|---|---|
| Mean Cell GFP Intensity (1e-4) | 5.0 | 4.0 | 5.6 | – | 4.9 | 4.1 | 3.9 | 4.3 | 3.2 | 3.4 | 3.3 | 3.4 | 5.4 | 5.1 | 4.6 | 4.5 | 5.5 | 5.6 | 5.8 | 5.8 | 5.6 |
| Std Deviation (1e-4) | 0.8 | 0.8 | 1.0 | – | 1.3 | 0.8 | 1.2 | 2.0 | 1.1 | 0.9 | 0.8 | 0.6 | 0.8 | 1.1 | 0.8 | 1.5 | 1.6 | 1.3 | 1.4 | 1.6 | 1.2 |
| Intensity Change (Log2) | – | – | – | – | -0.19 | -0.47 | -0.51 | -0.37 | -0.79 | -0.73 | -0.77 | -0.73 | -0.05 | -0.15 | -0.29 | -0.33 | -0.03 | -0.01 | 0.04 | 0.04 | -0.0 |
Localization Change
| Localization | RAP60 | RAP140 | RAP220 | RAP300 | RAP380 | RAP460 | RAP540 | RAP620 | RAP700 | HU80 | HU120 | HU160 | rpd3Δ_1 | rpd3Δ_2 | rpd3Δ_3 |
|---|---|---|---|---|---|---|---|---|---|---|---|---|---|---|---|
| Actin | – | – | – | – | – | – | – | – | – | – | – | – | – | – | – |
| Bud | – | – | – | – | – | – | – | – | – | – | – | – | – | 0 | – |
| Bud Neck | – | – | – | – | – | – | – | – | – | – | – | – | – | 0 | – |
| Bud Site | – | – | – | – | – | – | – | – | – | – | – | – | – | 0 | – |
| Cell Periphery | – | – | – | – | – | – | – | – | – | – | – | – | – | 0 | – |
| Cyto | – | – | – | – | – | – | – | – | – | – | – | – | – | – | – |
| Endoplasmic Reticulum | – | – | – | – | – | – | – | – | – | – | – | – | – | 0 | – |
| Endosome | – | – | – | – | – | – | – | – | – | – | – | – | – | 0 | – |
| Golgi | – | – | – | – | – | – | – | – | – | – | – | – | – | 0 | – |
| Mitochondria | – | – | – | – | – | – | – | – | – | – | – | – | – | 0 | – |
| Nuclear Periphery | – | – | – | – | – | – | – | – | – | – | – | – | – | 0 | – |
| Nuc | – | – | – | – | – | – | – | – | – | – | – | – | – | – | – |
| Nucleolus | – | – | – | – | – | – | – | – | – | – | – | – | – | 0 | – |
| Peroxisomes | – | – | – | – | – | – | – | – | – | – | – | – | – | 0 | – |
| SpindlePole | – | – | – | – | – | – | – | – | – | – | – | – | – | 0 | – |
| Vac | – | – | – | – | – | – | – | – | – | – | – | – | – | – | – |
| Cortical Patches | – | – | – | – | – | – | – | – | – | – | – | – | – | 0 | – |
| Cytoplasm | – | – | – | – | – | – | – | – | – | – | – | – | – | 0 | – |
| Nucleus | – | – | – | – | – | – | – | – | – | – | – | – | – | 0 | – |
| Vacuole | – | – | – | – | – | – | – | – | – | – | – | – | – | 2.5 | – |
External localization resources
Images






























Protein Concentration and Protein Localization Data
| R1 | R2 | R3 | ||||||||||||||||
|---|---|---|---|---|---|---|---|---|---|---|---|---|---|---|---|---|---|---|
| G1 Pre-START | G1 Post-START | S/G2 | Metaphase | Anaphase | Telophase | G1 Pre-START | G1 Post-START | S/G2 | Metaphase | Anaphase | Telophase | G1 Pre-START | G1 Post-START | S/G2 | Metaphase | Anaphase | Telophase | |
| Concentration | 2.8795 | 3.5722 | 3.556 | 2.2762 | 2.5653 | 2.8033 | 3.2936 | 3.3701 | 3.3015 | 2.9482 | 3.1685 | 3.2855 | 1.1009 | 1.25 | 1.0491 | 0.853 | 0.6036 | 0.929 |
| Actin | 0.0203 | 0 | 0.0229 | 0.0005 | 0.0121 | 0.0019 | 0.0076 | 0.0005 | 0.0064 | 0.0011 | 0.0001 | 0.0001 | 0.0322 | 0.0001 | 0.0016 | 0.0001 | 0.0001 | 0.0012 |
| Bud | 0.0003 | 0 | 0.0004 | 0.0002 | 0.0004 | 0.0001 | 0.0002 | 0.0001 | 0.0002 | 0.0024 | 0 | 0 | 0.0013 | 0.0001 | 0.0002 | 0 | 0 | 0.0001 |
| Bud Neck | 0.0009 | 0.0002 | 0.0009 | 0.001 | 0.0016 | 0.0034 | 0.0015 | 0.001 | 0.0004 | 0.001 | 0.0005 | 0.0021 | 0.0032 | 0.0003 | 0.0024 | 0.0052 | 0.0014 | 0.0031 |
| Bud Periphery | 0.0007 | 0 | 0.0012 | 0.0002 | 0.0009 | 0.0002 | 0.0002 | 0.0001 | 0.0002 | 0.0052 | 0 | 0 | 0.0028 | 0.0001 | 0.0002 | 0 | 0.0001 | 0.0002 |
| Bud Site | 0.0011 | 0.0006 | 0.0029 | 0.0011 | 0.0016 | 0.0002 | 0.0007 | 0.0016 | 0.0006 | 0.0212 | 0 | 0.0001 | 0.0046 | 0.0004 | 0.003 | 0.0001 | 0.0001 | 0.0002 |
| Cell Periphery | 0.0002 | 0 | 0.0005 | 0 | 0.0001 | 0 | 0.0001 | 0 | 0.0001 | 0.0026 | 0 | 0 | 0.0007 | 0 | 0.0001 | 0 | 0 | 0 |
| Cytoplasm | 0.0205 | 0.0079 | 0.017 | 0.0038 | 0.0079 | 0.0064 | 0.0251 | 0.0193 | 0.0088 | 0.0099 | 0.008 | 0.0151 | 0.0293 | 0.0176 | 0.0174 | 0.0119 | 0.0031 | 0.0096 |
| Cytoplasmic Foci | 0.0032 | 0.0001 | 0.008 | 0.0004 | 0.0336 | 0.001 | 0.0051 | 0.0045 | 0.0003 | 0.0012 | 0.0002 | 0.0005 | 0.0114 | 0.0005 | 0.0027 | 0.0009 | 0.0001 | 0.0008 |
| Eisosomes | 0.0002 | 0 | 0.0002 | 0 | 0.0001 | 0.0001 | 0.0002 | 0 | 0.0002 | 0.0001 | 0 | 0 | 0.0014 | 0 | 0.0001 | 0 | 0 | 0 |
| Endoplasmic Reticulum | 0.003 | 0.0001 | 0.0021 | 0.0004 | 0.0009 | 0.0004 | 0.0018 | 0.0008 | 0.0006 | 0.0008 | 0.0001 | 0.0004 | 0.0048 | 0.0007 | 0.0005 | 0.0014 | 0.0002 | 0.0009 |
| Endosome | 0.0121 | 0.0001 | 0.0066 | 0.0003 | 0.0241 | 0.0027 | 0.0153 | 0.0009 | 0.0016 | 0.0028 | 0.0001 | 0.0004 | 0.0193 | 0.0007 | 0.0015 | 0.0026 | 0.0003 | 0.0013 |
| Golgi | 0.0023 | 0 | 0.0044 | 0.0001 | 0.0192 | 0.0013 | 0.0048 | 0.0001 | 0.0008 | 0.0012 | 0 | 0 | 0.006 | 0 | 0.0008 | 0 | 0 | 0.0002 |
| Lipid Particles | 0.0074 | 0 | 0.0092 | 0 | 0.0712 | 0.0046 | 0.0097 | 0.0002 | 0.0001 | 0.0002 | 0 | 0 | 0.0116 | 0 | 0.0024 | 0.0001 | 0 | 0.0004 |
| Mitochondria | 0.0015 | 0.0002 | 0.0062 | 0.0005 | 0.0259 | 0.0005 | 0.0019 | 0.0003 | 0.0023 | 0.0047 | 0.0001 | 0.0002 | 0.0105 | 0.0003 | 0.0006 | 0.0002 | 0.0003 | 0.0006 |
| None | 0.0919 | 0.0307 | 0.0668 | 0.0009 | 0.0249 | 0.0266 | 0.1337 | 0.0145 | 0.0787 | 0.0029 | 0.148 | 0.0434 | 0.0889 | 0.0707 | 0.0703 | 0.0015 | 0.0015 | 0.0364 |
| Nuclear Periphery | 0.0113 | 0.0023 | 0.0161 | 0.0083 | 0.0266 | 0.0039 | 0.0061 | 0.0136 | 0.0114 | 0.0046 | 0.0063 | 0.0051 | 0.0186 | 0.0062 | 0.0049 | 0.0179 | 0.0094 | 0.0108 |
| Nucleolus | 0.022 | 0.0146 | 0.0195 | 0.0102 | 0.0787 | 0.0289 | 0.0181 | 0.0149 | 0.0148 | 0.0167 | 0.0174 | 0.0406 | 0.0172 | 0.0145 | 0.017 | 0.0167 | 0.0508 | 0.027 |
| Nucleus | 0.7598 | 0.9377 | 0.7728 | 0.9223 | 0.5256 | 0.8985 | 0.7224 | 0.7915 | 0.8546 | 0.9018 | 0.8007 | 0.8504 | 0.66 | 0.8664 | 0.8401 | 0.9067 | 0.8535 | 0.8683 |
| Peroxisomes | 0.0016 | 0 | 0.012 | 0 | 0.0728 | 0.0009 | 0.0009 | 0.0002 | 0.0001 | 0.0001 | 0 | 0 | 0.0049 | 0 | 0.0053 | 0 | 0 | 0.0001 |
| Punctate Nuclear | 0.0305 | 0.0051 | 0.0222 | 0.0496 | 0.0697 | 0.0181 | 0.0421 | 0.1354 | 0.0168 | 0.015 | 0.0182 | 0.0412 | 0.0591 | 0.0195 | 0.0284 | 0.0336 | 0.0787 | 0.038 |
| Vacuole | 0.0077 | 0.0003 | 0.0061 | 0.0002 | 0.0011 | 0.0004 | 0.002 | 0.0003 | 0.0005 | 0.0041 | 0.0001 | 0.0003 | 0.0103 | 0.0015 | 0.0005 | 0.0007 | 0.0002 | 0.0006 |
| Vacuole Periphery | 0.0013 | 0 | 0.0019 | 0.0001 | 0.0009 | 0.0002 | 0.0004 | 0.0001 | 0.0004 | 0.0005 | 0 | 0.0001 | 0.0018 | 0.0002 | 0.0001 | 0.0003 | 0.0001 | 0.0003 |
Sequencing Data
| R1 | R2 | |||||||||
|---|---|---|---|---|---|---|---|---|---|---|
| G1 Post-START | S/G2 | Metaphase | Anaphase | Telophase | G1 Post-START | S/G2 | Metaphase | Anaphase | Telophase | |
| Gene Expression | 11.034 | 14.2477 | 23.5845 | 14.0436 | 7.1531 | 11.0279 | 17.1761 | 11.5927 | 10.541 | 12.1888 |
| Translational Efficiency | 0.6905 | 0.82 | 0.4717 | 0.7896 | 1.289 | 1.147 | 0.5531 | 0.8961 | 0.9143 | 0.5968 |
Hit Data
| Dataset | Hit |
|---|---|
| Protein Concentration | ✘ |
| Protein Localization | ✘ |
| Gene Expression | ✘ |
| Translational Efficiency | ✘ |
Endocytosis
| Temp | Actin Patch (Sac6-tdTomato) | Cortical Patch (Sla1-GFP) | Late Endosome (Snf7-GFP) | Vacuole (Vph1-GFP) |
|---|---|---|---|---|
| 37℃ | ||||
| RT |
Cell Cycle Omics
CYCLoPs (Sut1-GFP)
| Gene / Allele | Actin Patch (Sac6-tdTomato) | Cortical Patch (Sla1-GFP) | Late Endosome (Snf7-GFP) | Vacuole (Sac6-tdTomato) |
|---|
| Gene | Images |
|---|
| Gene | Images |
|---|
Images are not yet available
Images are not yet available